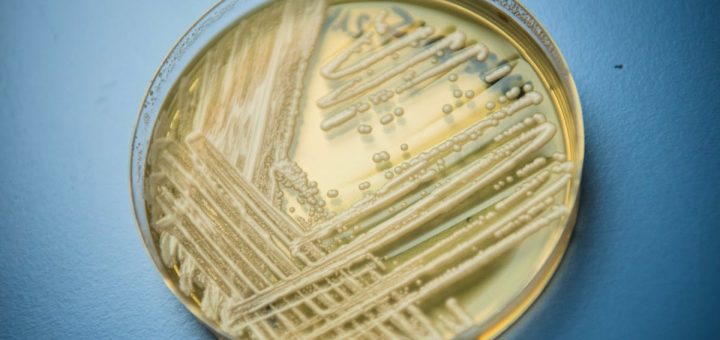

Les marchés de Noël les plus prisés d’Europe selon Time Out : Lucerne en Suisse parmi le top 10
Les marchés de Noël les plus prisés d’Europe selon Time Out Alors que l’hiver s’installe et que l’envie de rester au chaud se fait sentir, l’ambiance des marchés de Noël réchauffe les cœurs avec...